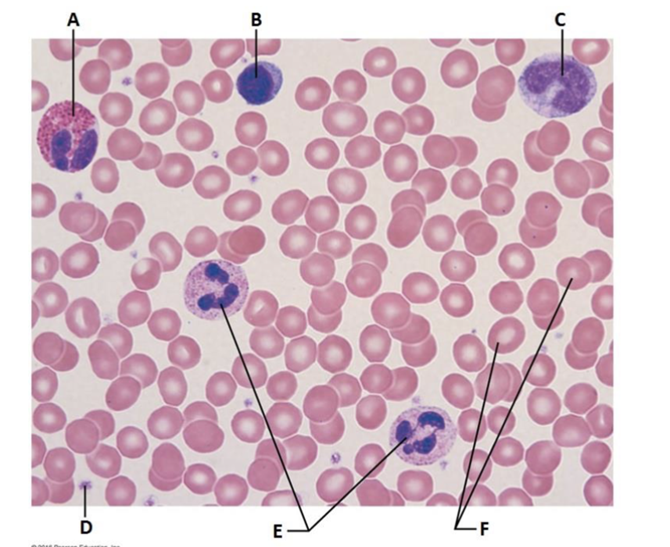

A&P II Lab Practical 1 Review
What are the 6 hormones associated with the Anterior Pituitary gland?
TSH, FSH, LH, ACTH, GH, PRL
What are the 2 hormones associated with the Posterior Pituitary gland
Oxytocin, ADH

Name the 2 parts of this gland
Anterior and Posterior Pituitary gland

What is A?
Adrenal gland

What hormones are secreted by A?
Mineralocorticoids, Glucocorticoids, Gonadocordicords

What is B?
Pancreas

List the hormones secreted by B
Insulin, Glucagon

What is A?
Parathyroid gland

What is B?
Thymus

What is C?
Thyroid gland

What hormones are secreted by A?
PTH

What hormones are secreted by B?
thymulin, thymosin, thymopoietin

What hormones are secreted by C?
TH, Calcitonin

What is A?
Testis

What is B?
Ovary

List the hormones secreted by A
testosterone

List the hormones secreted by B
estrogen, progesterone

What gland is this?
Adrenal gland

What is a?
Capsule

What is e?
Adrenal medulla

What hormones are secreted by e?
epinephrine, norepinephrine

What is b?
zona glomerulosa

What is c?
zona fasciculata

What is d?
zona reticularis

What hormones are released by b?
mineralocorticoids/aldosterone

What hormones are released by c?
glucocorticoids/cortisol

What hormones are released by d?
gonadocorticoids/estrogen/testosterone

What gland is this?
Anterior pituitary gland

What is A?
Acidophils

What is C?
Basophil

What hormones are made by A?
growth hormones and prolactin

What hormones are made by B?
TSH, ACTH, FSH, LH

What gland is this?
Posterior pituitary gland

What hormones are associated with this gland?
oxytocin and ADH

What is made here? What is stored here?
Nothing is made here but oxytocin and ADH are stored here
How is the release of ACTH stimulated?
another hormone
How is the release of Calcitonin stimulated?
humoral factors
How is the release of Estrogens stimulated?
another hormone
How is the release of Insulin stimulated?
humoral factors
How is the release of Norepinephrine stimulated?
the nervous system
How is the release of Parathyroid hormone stimulated?
humoral factors
How is the release of T4/T3 stimulated?
another hormone
How is the release of Testosterone stimulated?
another hormone
How is the release of TSH/FSH stimulated?
another hormone
Define hormone
A chemical substance liberated into the extracellular fluid that enter blood for transport through the body
Chemically hormones belong chiefly to two molecular groups, the ________ and the ______________ molecules
Steroids, Amino acid-based
Define target cell
cell responding to a particular hormone in a specific way
If hormones travel in the bloodstream, why don’t all tissues respond
to
all hormones?
The proper “hormone” receptors must be present on the
plasma
membrane or within the cells for the tissue cells to respond.

Label A, what is its main function
Eosinophil, kills parasitic worms

Label B, what is its main function
Lymphocyte, immune response

Label C, what is its main function
Monocyte, phagocytizes

Label D, what is its main function
Platelet, vital to clotting

Label E, what is its main function
Neutrophil, phagocytosis, MOST COMMON
Label F, what is its main function
Erythrocyte, transport O2 and CO2

All 5 are categorized as what?
Leukocytes

What is A?
Monocyte, Agranulocyte

What is B?
Basophil, Granulocyte, LEAST COMMON

What is C?
Neutrophil, Granulocyte, MOST COMMON

What is D?
Eosinophil, Granulocyte

What is E?
Lymphocyte, Agranulocyte

What is A?
Neutrophil, phagocytize, MOST COMMON

What is B?
Eosinophil, kill parasitic worms

What is C?
Basophil, release mediators of inflammation, LEAST COMMON

What is D?
Lymphocyte, immune response

What is E?
Monocyte, phagocytize

Which is a normal hematocrit level?
A.

What is condition associated with sample B?
Anemia

What is condition associated with sample C?
Polycythemia

What blood type is sample 1?
O -, UNIVERSAL DONATER

What blood type is sample 2?
O +

What blood type is sample 3?
A -

What blood type is sample 4?
A +

What blood type is sample 5?
B -

What blood type is sample 6?
B +

What blood type is sample 7?
AB -

What blood type is sample 8?
AB +, UNIVERSAL ACCEPTER
Most numerous leukocyte
Neutrophil
Precursor cell of platelets
megakaryocyte
Destroys parasitic worms
Eosinophil
Transports oxygen
Erythrocytes
Exits a blood vessel to develop into a macrophage
Monocyte
Produces antibodies
Lymphocytes
What hormone acts as a stimulus for this process of RBC production?
erythropoietin (EPO)
What name is given to the process of RBC production?
erythropoiesis
What name is given to the production of blood cells in general?
hematopoiesis
What is the average lifespan of a RBC?
120 days
Why is a differential WBC count more informative than a total WBC count?
It helps in diagnosing illnesses, since any abnormality in percentages of WBC types may indicate a problem and the source of pathology

What gland is this?
Parathyroid gland

What is A?
Oxyphil cells

What is B?
Parathyroid cells

What hormone is made by B?
PTH

What gland is this from?
Pancreases

What is the specific names are given to this "little island" within the organ?
Pancreatic islet

Label A
alpha cells

Label B
beta cells

Label C
Pancreatic acinar cells

What hormones are made by a?
glucagon

What hormones are made by b?
insulin

What is made by c?
produce exocrine secretion of digestive enzymes

Is a, b, or c the exocrine cell?
c, the pancreatic acinar cells

What gland is this?
Thyroid gland

What is a?
Colloid-filled follicles

What is b?
Follicular cells

What is made by b?
T4, T3

what is made by a?
thyroglobulin

What gland is this?
Thyroid gland

What hormones are produced in this gland?
T3, T4, Calcitonin

What hormone stimulates this gland?
TSH

What other gland releases a hormone that stimulates this gland?
Anterior Pituitary gland
TSH
thyroid hormone, stimulates the thyroid gland
LH
ovulation, estrogen/progesterone/testosterone
ACTH
glucocorticoids, androgens release
PRL
Milk production
FSH
follicle maturation and estrogen/sperm production
GH
stimulates body growth and protein synthesis
Oxytocin
uterine contraction, milk ejection
ADH
stimulates kidneys to reabsorb water